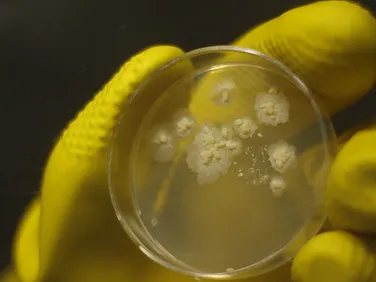

Pioneering Stem Cell Altruism Research for Humanity
A Scientific and Industrial Research Organization (SIRO) Certified Laboratory
Welcome to KaviKrishna Laboratory


Assam's First AI-Powered Digital Health App Launched: A New Era for Rural Healthcare
16 February, 2025
KaviKrishna has recently announced the release of the first AI-Powered health app: heal Art. This app was created by KaviKrishna Telemedicine Services in partnership with Assamese tech titans Manas Goswami from Microsoft and Dhruv Borthakur from OpenAI with the goal of transforming healthcare delivery in rural areas. KaviKrishna Telemedicine Services has provided necessary healthcare for more than 30 years, especially to cancer patients in rural Assam. With the help of cutting-edge AI technology, the new KaviKrishna HealArt app offers continuous communication between patients and healthcare providers, personalised assessments, and real-time health monitoring—all on a single, easy-to-use platform. KaviKrishna is utilizing AI, not only to manage health data but also to enhance the ability of managing patient condition remotely. Which will help in overall improvement in healthcare delivery, making it accessible even in the most remote areas. As Dr. Bikul Das, Founder of KaviKrishna Telemedicine Services, said, “KaviKrishna HealArt is the next step in our long-standing commitment to improving healthcare in rural Assam. With AI, we can provide smarter, more efficient care to our patients, improving both their quality of life and access to health services.” With KaviKrishna HealArt, the future of rural healthcare has arrived, offering hope and better health outcomes for communities across Assam

Partha Jyoti Saikia Presents Research at the 44th Annual Meeting of the Indian Association for Cancer Research
15 January, 2025
We are excited to share that Partha Jyoti Saikia, a dedicated researcher at KaviKrishna Laboratory, recently participated in the 44th Annual Meeting of the Indian Association for Cancer Research (IACR) and the International Conference on Convergence of Fundamental and Translational Approaches in Cancer Theranostics held in Kolkata from 16-18th January 2025. During the conference, Partha had the opportunity to present his research on the topic: "Reduced Oral Bacterial Diversity Linked to Cancer Recurrence and Tumor Grade." This research, conducted at KaviKrishna Laboratory in IIT Guwahati, sheds light on the connection between oral bacterial diversity and cancer recurrence, as well as its potential role in determining tumour grade. Partha expressed his gratitude to his supervisor, Dr. Bikul Das, his colleagues at KaviKrishna Laboratory, and the conference organizers for their support and the opportunity to be part of this prestigious event. We are incredibly proud of Partha's achievements and look forward to the continued impact of his research on the future of cancer. Congratulations to Partha on his successful presentation and contributions to advancing cancer research!

Lekhika Pathak Successfully Defends her PhD thesis from IIT, Guwahati
20 October, 2024
After many years of continuous hard work in the revolutionary field of Altruistic Stem Cells, our research scholar Lekhika Pathak successfully defended her PhD thesis titled ‘Insight into Stem Cell Niche Defense Mechanism in TB Reactivation and Head & Neck Cancer Recurrence’ and obtained her doctorate under the supervision of Dr. Bikul Das from KaviKrishna Laboratory. She received the degree from the Indian Institute of Technology-Guwahati (IIT-G) under the co-supervision of Dr. Sanjukta Patra. Dr. Pathak has developed a preclinical model of TB and cancer recurrence in her PhD work. Significantly, she could circulating-ASCs from the peripheral blood of TB and Cancer recurrence subjects, which could be used as a biomarker to predict therapy response in patients. Importantly, She worked on developing a rural telemedicine network at KaviKrishna Telemedicine Care, Sualkuchi, and by utilizing this network she completed the clinical investigation on TB and cancer subjects of her PhD work.

Visit of Commander VK Jaitely at KaviKrishna lab
26 July, 2024
Youth for Nation, National coordinator Commander VK Jaitley Ji has visited KaviKrishna Laboratory on 26th July 2024. The research team and summer interns of the lab had a very motivating interaction session with him.

Master's course on Indian Knowledge System by KaviKrishna
24 January, 2024
This Master's degree curriculum on IKS has been developed based on decades of experiences of learning, reflecting, researching, and doing fieldwork on the Indian Knowledge System, which culminated in writing two books, and several papers, and training four PhD students on IKS-related bio-medical research. This is an interdisciplinary course for Master's Degree for Indian Knowledge System. The course is already ongoing in the KaviKrishna Centre for Indian Knowledge System at Sualkuchi

The Medical Humanities team of KaviKrishna participated in the NCGV at IIT-Guwahati
15 August, 2023
The Medical Humanities team of KaviKrishna participated in the ‘National Conference of Gau-Vigyan and in modern life and medical science’ at IIT-Guwahati, which was organized by the Centre for Indian Knowledge System (IKS) of IIT-Guwahati in association with Bharatiya Govansh Rakshan Samvardhan Parishad (BGRSP). The students have participated in oral as well as poster presentation and interacted with the researcher/social worker and scientists working in different field of IKS. This team mainly work in the Sualkuchi campus of KaviKrishna and work with Star as well as rural community networks. Rupam Das, one of the student has received best poster award on.

Yuva Sangam with KaviKrishna Living Muga Museum
4 May, 2023
A group of 190 Students from different parts of India visited KaviKrishna Living Muga Museum in collaboration with IIT-Guwahati to learn about the Indigenous Knowledge System-based Muga Culture of Sualkuchi. The event was co-coordinated by Lekhika Pathak, Rupam Das, Sonali Das, Mallika Maral, Pragya Dutta, and Sailen Baishya. The students visited KaviKrishna Living Muga Museum of Tantipara where they saw the whole process of creating a Muga chador mekhela, from the cocoons to the looms. In this way, they were exposed to Muga weaving as not just a profession, but as an art. They also listened to presentations given by four prospective PhD students of the Medical Humanities to learn more about KaviKrishna's effort and work regarding their research and its application towards the Indigenous Knowledge System of Kamrup. Afterwards, the students went shopping in the streets of Sualkuchi and bought a total of more than 40,000 rupees worth of items. Their enthusiasm and the success of the event shows the promising future of KaviKrishna's Muga, Medical Humanities, and tourism projects.

Sonali Das is KaviKrishna’s first international intern.
27 January, 2023
Sonali Das, a high school graduate to begin attending Bowdoin College in September 2023, is KaviKrishna’s first international intern. From January 2023-June 2023, Sonali worked at our telemedicine clinic (KTC) and upcoming Indigenous Knowledge System (IKS) department located in Sualkuchi. Sonali Das, the daughter of Dr. Bikul Das, came to Sualkuchi to research the cultural, philosophical, rural developmental, and clinical aspects of healthcare as per the ancient tantric medical philosophy, Jiva Upakara Tantra. Since September 2022, she has been editing her father’s book, “Recovering the Spirit of Jiva Upkara Tantra,” which she was able to further improve based on her research here. Sonali spent most of her time living in the village, visiting local satras, temples, community centers, and schools, interviewing local members of the community, and engaging in festivals and travel related to the history of Kamarupa. She also co-coordinated multiple cultural and linguistic initiatives, such as the Yuva Sangam Muga Museum visit of 180 Indian students, a two-day workshop on spoken English at the local SBMS college, and KaviKrishna’s first international student week-long internship, with Prerna Karmacharya and Alexander Payne from the USA. After working for five months with graduate students to develop a Medical Humanities program proposal, Sonali Das prepared and gave an oral presentation at IIT-Guwahati’s National Gau-Vigyan Conference titled “An Indo-American Medical Humanities Program: Researching Kamrupa’s IKS-based Healthcare.” She is now back in the USA, engaging with the Thoreau Lab for Global Health to build the Medical Humanities program and create an Indo-American bridge connecting KaviKrishna to Walden Pond.
Research
Our dedicated stem cell research team is fervently engaged in pioneering advancements in the realms of diagnostic and therapeutic modalities. Our focus is directed towards combatting the formidable challenges posed by cancer and infectious diseases.
Know More
Academic programs
We Offer specialized PhD programs designed to cultivate advanced research skills and expertise in specialized areas of study in Stem cell altruism focusing on Cancer and Infectious diseases.
Know MoreCenters
We provide free of cost consultancy service for cancer patients from all over Assam. We operate mainly from the KTC centre based in College Road Sualkuchi. Starting its operations informally since 1994, KTC formally registered under KaviKrishna NGO in 2010. At KTC, we follow up with cancer patients on a daily basis who are examined by our dedicated team.
Know More


